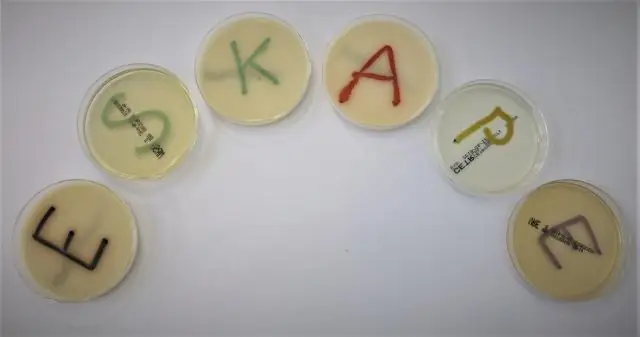
Управление заражением вирусом Зика

Бразильское общество по инфекционным заболеваниям созвало группу национальных экспертов для организации национальных рекомендаций по лечению вирусной инфекции Зика. Основное внимание в этом документе уделяется диагностике, как клинической, так и лабораторной, и соответствующему лечению различных проявлений этой инфекции, от острого легкого заболевания до синдрома Гийена-Барре, а также микроцефалии и врожденных пороков развития.
Фон
Вирус Зика является арбовирусом рода Flavivirus из семейства Flaviviridae, впервые обнаруженным в 1947 году в лесу Зика в Уганде во время программы мониторинга дикой желтой лихорадки (1-4). Это связано с другими флавивирусами, включая вирусы, которые вызывают лихорадку денге, желтую лихорадку и западную нильскую лихорадку.
Вспышки заболевания были впервые зарегистрированы в Тихоокеанском регионе в 2007 и 2013 годах, соответственно, на островах Яп и во Французской Полинезии, а затем в Америке (Бразилия и Колумбия) и в Африке (Кабо-Верде) в 2015 году (2, 3, 5, 6). С тех пор наблюдается быстрое географическое расширение: 40 стран Северной и Южной Америки сообщают об автохтонной передаче как единичных случаях или вспышках. Также важно упомянуть растущее число стран на других континентах, которые уведомляют о случаях импортированных случаев заражения вирусом Зика, демонстрируя тем самым его большой потенциал для распространения в мировом масштабе (7).
Благодаря вспышкам вируса Зика, центральная нервная система и аутоиммунные осложнения, о которых ранее сообщалось во Французской Полинезии, также стали наблюдаться в Северной и Южной Америке.
Инфекция Зика во время беременности коррелирует с врожденной микроцефалией, пороками развития плода и потерями плода. Это привело к тому, что министерство здравоохранения Бразилии объявило чрезвычайную ситуацию в области общественного здравоохранения, имеющую общегосударственное значение, в ноябре 2015 года после наблюдения за изменениями эпидемиологической картины возникновения микроцефалии в Пернамбуку и других штатах на северо-востоке Бразилии (8, 9).
В свете значительного увеличения числа неврологических синдромов и случаев микроцефалии, которые потенциально могут быть связаны с вирусом Зика, Всемирная организация здравоохранения (ВОЗ) в феврале 2016 года объявила о чрезвычайном положении в области международного общественного здравоохранения. это событие в контексте, это был четвертый раз, когда ВОЗ когда-либо объявляла чрезвычайное положение во всем мире в связи с вирусной эпидемией. Предыдущие решения были приняты в отношении H1N1 (2009 г.), полиомиелита (2014 г.) и Эболы (2014 г.).
18 февраля 2016 года министерство здравоохранения Бразилии издало постановление, обязавшее уведомлять о подозрительных случаях заболевания Зика по всей стране. Таким образом, это заболевание было добавлено к другим арбовирусам, таким как лихорадка денге, желтая лихорадка, лихорадка Западного Нила и чикунгунья, которые уже были включены в национальный список заболеваний с обязательным уведомлением (10).
эпидемиология
Географическое распределение
У людей вирус Зика был впервые обнаружен в Уганде и Танзании в 1952 году (11). В период с 1952 по 1981 год в странах Африки и некоторых частях Азии сообщалось о множестве серологических данных, касающихся заражения этим вирусом (4).
Первая эпидемия за пределами Африки и Азии произошла в 2007 году на островах Яп в Микронезии. Было подсчитано, что более 70% населения в возрасте старше 3 лет заразились (2). Другая крупная вспышка лихорадки Зика произошла одновременно с эпидемией денге (серотипы 1 и 3) во Французской Полинезии в 2013-2014 годах, затронувшей около 32 000 человек (3).
В 2014 году были зарегистрированы случаи заражения вирусом Зика на острове Пасхи, который является территорией Чили (12). В мае 2015 года, спустя несколько месяцев после сообщений о повышении частоты возникновения экзантематозных лихорадочных заболеваний в штатах северо-восточной Бразилии, которые до этого имели неизвестную причину, в этой стране было подтверждено наличие циркуляции вируса Зика. Первоначально это было подтверждено в Баии 29 апреля 2015 года на основе анализа образцов от пациентов с экзантематозным состоянием в Камасари, штат Баия, а затем в Риу-Гранди-ду-Норти 9 мая 2015 года, с выявлением азиатского генотипа (13, 14). Также в мае случаи заболевания в Сумаре и Кампинасе (Сан-Паулу), Масейо (Алагоас) и Белене (Пара) были подтверждены лабораторными испытаниями. С тех пор наблюдается быстрое расширение областей циркуляции и автохтонной передачи вируса, особенно в штатах северо-восточного региона Бразилии. По оценкам, в 2015 году более миллиона бразильцев заразились вирусом Зика, что отражает способность вируса вызывать крупномасштабные вспышки в местах присутствия биологического вектора.
В настоящее время во всем мире вирус циркулирует в 65 странах и территориях, в основном в Северной и Южной Америке (15).
Методы передачи
Зика передается преимущественно через укусы инфицированных комаров рода Aedes, особенно Aedes aegypti и Aedes albopictus (16).
У людей, за исключением беременных, период виремии короткий, и он чаще всего определяется на 5-й день после начала симптомов. РНК вируса Зика была обнаружена в крови уже в 1-й день, а также только через 11 дней после начала заболевания. Пролонгированная РНК вируса Зика была обнаружена в сыворотке четырех симптоматических беременных в течение 46 дней после появления симптомов и у одной бессимптомной беременной через 53 дня после заражения (17). У беременных женщин РНК вируса Зика выявлялась до 10 недель после заражения (18).
В дополнение к передаче вектора, другие формы передачи, которые до сих пор носили теоретический или анекдотичный характер, стали привлекать больше внимания. В настоящее время РНК вируса Зика обнаруживается в крови, моче, сперме, слюне, секретах женских половых путей, спинномозговой жидкости, амниотической жидкости и грудном молоке (16, 19-25).
После того, как в Кампинасе, Сан-Паулу, были выявлены два вероятных случая передачи через переливание крови, было много дискуссий о важности этого пути передачи (26).
Сообщения об обнаружении Зика в моче с помощью ПЦР в течение 20 дней после начала симптомов в исследовании, проведенном во Французской Полинезии, даже без какого-либо подтверждения инфекционности, привели к дискуссии о необходимости лучшего понимания важности этого биологический материал как инфекционный агент (21).
Зика была обнаружена в сперме в течение периода до 10 недель после выздоровления от симптомов инфекции, и были описаны вероятные случаи передачи инфекции половым путем от мужчины к женщине. Одиннадцать стран сообщили о фактах передачи вируса Зика от человека к человеку, вероятно, половым путем (15).
Тесты, проведенные на амниотической жидкости беременных женщин с возможной инфекцией вирусом Зика, чьи плоды были диагностированы как представляющие микроцефалию, оказались положительными для вируса Зика (27). Это показывает, что вирус способен преодолевать плацентарный барьер и все более очевидно, что он вызывает пороки развития плода.
Присутствие вируса уже было продемонстрировано путем обнаружения вирусной РНК в грудном молоке матерей с острой инфекцией. Ожидается более высокая вирусная нагрузка вируса Зика в материнском молоке для женщин, инфицированных в период, близкий к родам, и не ожидается, что это произойдет при инфекциях первого триместра. В Новой Каледонии сообщалось о наличии инфекционных частиц вируса Зика в грудном молоке со значительными вирусными нагрузками (28). Однако, поскольку не было подтвержденных случаев передачи при грудном вскармливании, руководство по-прежнему заключается в том, что грудное вскармливание следует поддерживать, учитывая, что преимущества грудного вскармливания перевешивают риски передачи вируса через грудное молоко, что остается недоказанным (22). В свете современных знаний идентификация вируса в моче, грудном молоке, слюне и сперме потенциально полезна для диагностики заболевания, но возможность важности таких результатов для передачи вируса другим людям не может быть подтверждена.
Клинические проявления
Признаки и симптомы
По оценкам, клинические проявления встречаются примерно у 20% инфицированных людей. Следовательно, бессимптомная инфекция встречается чаще. Эти оценки были основаны на одном исследовании, которое было проведено в ходе серологического обследования домашних хозяйств, включающего серологические тесты на Зика (IgM) (2).
Продолжительность инкубации у людей неизвестна, но, по оценкам, она составляет 2-14 дней после укуса переносимого комарами (29).
Клиническое состояние обычно включает макулопапулезную сыпь, часто сопровождающуюся зудом, низкой температурой (37, 8-38, 5 ° С), артралгией (особенно в суставах рук и ног) и негнойным конъюнктивитом. Другие проявления, о которых обычно сообщают, включают миалгию, головную боль, ретро-орбитальную боль и астению. Также могут возникать периартикулярные отеки, оральная лимфаденопатия, язвы в полости рта, боли в животе, тошнота и диарея (2, 13, 14).
У большинства пациентов симптомы обычно слабо выражены и проявляются спонтанно через 2-7 дней. Однако у некоторых пациентов артралгия может сохраняться в течение 1 месяца.
До настоящего времени продолжительность иммунитета, полученного в результате естественного заражения вирусом Зика, остается неизвестной.
Определение подозреваемых случаев Зика в министерстве здравоохранения Бразилии
-
Подозреваемый случай: «Пациенты, у которых проявляется прообразная макулопапулезная экзантема, сопровождающаяся двумя или более из следующих признаков и симптомов:
- лихорадка
- Конъюнктивальная гиперемия без секреции и зуда
- полиартралгия
- Периартикулярный отек »
Определение подтвержденных случаев Зика бразильским министерством здравоохранения
-
Подтвержденный случай: «Предполагаемый случай, когда один из следующих тестов является положительным или показывает специфическую реакцию на диагноз Зика:
- Выделение вируса
- Обнаружение вирусной РНК с помощью реакции обратной транскриптазы (ОТ-ПЦР)
- Серологический тест IgM (в популяциях с коциркуляцией вируса денге существует высокая вероятность возникновения ложноположительных реакций) »
- Для эпидемиологического контроля после подтверждения автохтонного кровообращения, другие острые случаи Зика должны быть подтверждены с помощью клинико-эпидемиологических критериев, за исключением случаев, когда у беременных женщин или в ситуациях неврологических проявлений и смерти.
Врожденные осложнения
Врожденные аномалии, включая микроцефалию, обычно имеют сложную многофакторную этиологию и могут быть вызваны инфекцией во время беременности или хромосомными нарушениями, воздействием токсинов окружающей среды или метаболическими заболеваниями, как показано в таблице 1. Временные и пространственные отношения между вспышками Зика и более высокой частотой микроцефалия в штатах с документированной автохтонной передачей начала свидетельствовать о том, что наличие причинно-следственной связи между этими двумя эпидемиологическими событиями становится все более вероятным (30).
Таблица 1 Этиологические агенты и факторы риска микроцефалии
Таблица в натуральную величину
Эта связь становится все более последовательной, вследствие обнаружения вирусной РНК с использованием метода ПЦР для Зика в амниотической жидкости, плаценте, пуповинной крови и ткани головного мозга. Также была продемонстрирована способность вируса заражать и преодолевать плацентарный барьер, чтобы он мог затем воздействовать на нервную ткань во время своего формирования (32, 33).
В Бразилии после подтверждения вспышки вируса Зика заболеваемость микроцефалией стала более чем в 20 раз выше, чем можно было бы ожидать (34).
Во время исследования, проведенного в отношении 35 детей с микроцефалией, 74% матерей в северо-восточной Бразилии, которые подозревались в том, что у них был Зика во время их беременности, сообщили, что у них была кожная сыпь в течение первого и второго триместров (35).
Ретроспективно, после уведомления Бразилии о случаях заболевания в ВОЗ, случаи микроцефалии были также выявлены во Французской Полинезии. Эти случаи недавно были описаны в литературе (36).
Согласно руководству Министерства здравоохранения, необходимо уведомлять о случаях развития плода, которые идентифицированы как имеющие нарушения центральной нервной системы во время беременности.
В апреле 2016 года Центры по контролю и профилактике заболеваний (государственный орган в США, занимающийся исследованиями, статистикой, контролем и профилактикой заболеваний) пришли к выводу, что существует причинно-следственная связь между внутриутробной инфекцией вирусом Зика и другими церебральными нарушениями микроцефалии. Этот вывод основывался на фактических данных относительно инфекции вирусом Зика во время внутриутробного развития, что соответствовало наблюдаемым дефектам, с появлением редкого и специфического фенотипа, включающего микроцефалию и церебральные нарушения, у плодов или новорожденных с подтвержденной или предполагаемой врожденной инфекцией, вызванной вирусом Зика, и на данных, которые решительно поддерживали биологическое правдоподобие, включая идентификацию вируса Зика в церебральной ткани плодов и пораженных детей (37).
Определение случая
Уведомленный случай
«Плод, который представляет по крайней мере один из следующих критериев, относящихся к аномалиям центральной нервной системы, как выявлено при ультразвуковом исследовании (9):
- Наличие церебральной кальцификации И / ИЛИ
- Наличие желудочковых аномалий И / ИЛИ
- По крайней мере, два из следующих признаков аномалий задней ямки: гипоплазия мозжечка, гипоплазия червя мозжечка, расширение задней ямки более чем на 10 мм и агенез / гипоплазия мозолистого тела ».
Результаты ультразвукового исследования и / или томографии черепа трансфонтанелл включают (27, 35, 38, 39):
- Кальцификация головного мозга, особенно перивентрикулярная, в паренхиме, таламических областях и базальных ганглиях.
- Вентрикуломегалия.
- Лиссэнцефалия.
- Гипоплазия ствола мозга и мозжечка
- Нарушение затухания белого вещества.
Другие результаты УЗИ
- Артрогрипоз.
- Задержка внутриутробного развития.
- Нарушения артериального кровотока в мозговых или пупочных артериях.
- Олигогидрамниос или ангидрамниос.
- Findings Ультразвуковые исследования могут быть обнаружены с 18 по 20 неделю беременности.
Возможны поражения глаз, особенно аномалия пигмента и атрофия желтого пятна, а также аномалии зрительного нерва (40, 41).
Осложнения центральной нервной системы
Синдром Гийена-Барре (GBS) является аутоиммунным заболеванием, характеризующимся острой воспалительной демиелинизирующей полирадикулонейропатией. На двигательную функцию обычно влияют, начиная дистально и прогрессируя проксимально в течение 4-недельного периода. У пациентов наблюдаются генерализованная слабость, арефлексия и различные степени сенсорных расстройств и поражения черепных нервов. Его формы варьируются от тех, у кого есть как двигательные, так и сенсорные нарушения, до тех, у кого есть только сенсорные нарушения. Риск увеличивается с возрастом и чаще встречается среди мужчин, чем среди женщин. Примерно 25% пациентов нуждаются в поступлении в отделение интенсивной терапии, а 3-5% умирают. Ожидаемая годовая заболеваемость составляет один случай на 100 000 жителей (42).
Более высокая заболеваемость СГБ наблюдалась одновременно со вспышками Зика во Французской Полинезии, Бразилии, Сальвадоре, Колумбии, Суринаме и Венесуэле (43).
В ретроспективном исследовании случай-контроль, проведенном во Французской Полинезии и опубликованном в феврале 2016 года, сообщалось о 42 случаях СГБ, имевших место во время вспышки 2013-2014 годов, с выявлением IgM или IgG для Zika у 98% пациентов и нейтрализующими антителами к Zika. в 100% случаев по сравнению с 56% контрольной группы. Наиболее частыми симптомами были генерализованная мышечная слабость (74%) и лицевой паралич (64%) (44).
Двусторонний лицевой паралич также часто наблюдался. Большинство пациентов (88%) сообщили, что в среднем за 6 дней до начала неврологических симптомов у них было состояние, совместимое с вирусом Зика (44).
В Венесуэле в период с 1 по 31 января 2016 г. было зарегистрировано 252 случая СГБ, при этом ПЦР была положительной для Зика в трех случаях, включая один смертельный случай (45).
В Бразилии в период с января по ноябрь 2015 года было зарегистрировано 1708 случаев заболевания СГБ. Это общее число отражает очень значительное увеличение числа случаев заболевания в некоторых штатах, особенно в Алагоасе (516, 7%), Баия (196, 1%), Риу-Гранди-ду-Норти (108, 7%), Пиауи (108, 3%), Эспириту-Санту (78, 6%) и Рио-де-Жанейро (60, 9%) (46).
До настоящего времени детерминанты, относящиеся к увеличению заболеваемости СГБ в Бразилии, Колумбии, Сальвадоре и Суринаме, не были окончательно установлены, особенно в отношении сценария одновременной циркуляции денге, чикунгуньи и Зика, которые все потенциально связаны с проявлениями неврологических синдромов (43).
Другие арбовирусные заболевания, такие как лихорадка денге, чикунгунья, японский энцефалит и лихорадка Западного Нила, уже были обвинены в качестве агентов, связанных с возникновением СГБ.
Как и другие флавивирусы, вирус Зика может вызывать другие неврологические синдромы, такие как менингит, менингоэнцефалит и миелит, как описано во вспышке болезни во Французской Полинезии (44).
Лабораторные нарушения
Лабораторные аномалии неспецифичны. Были сообщения о легкой и умеренной лейкопении и тромбоцитопении, а также о небольшом повышении концентрации сывороточной молочной дегидрогеназы, гамма-глутамилтрансферазы и маркеров воспалительной активности (белки, фибриноген и ферритин) (8).
Из-за скудности клинических исследований были описаны небольшие отклонения в гематологических показателях и еще меньшие изменения в ферментах печени. В целом, нет никаких существенных отклонений в этих параметрах.
Дифференциальный диагноз
- Денге: повышенная температура и тяжесть миалгии и астении. Могут быть осложнения из-за кровоизлияния и гемодинамических нарушений, включая шок. Обычно не вызывает конъюнктивит. Значительные нарушения в лабораторных исследованиях, с гемоконцентрацией, низким количеством тромбоцитов и нарушениями ферментов печени.
- Чикунгунья: высокая температура, наблюдаемая при лихорадке денге, но с большой разницей, что полиартралгия / полиартрит начинается внезапно в тяжелой и изнурительной форме. Это может быть связано с суставным / периартикулярным отеком с самого начала заболевания. Может присутствовать прообразная кожная сыпь, продолжительность которой обычно короче, чем у Зика. Это может следовать за курсом, который включает умеренный конъюнктивит.
Основные отличительные признаки вирусной инфекции денге, чикунгуньи и вируса Зика приведены в таблице 2.
- Парвовирус: может вызывать острый симметричный артрит или артралгию, чаще всего в мелких суставах рук и ног, а также в запястьях и коленях. Часто наблюдается кожная сыпь.
- Краснуха: обычно вызывает низкую температуру и насморк. Наличие кожной сыпи вначале на лице, а затем распространяется на туловище. Возможны артрит и лимфаденопатия.
- Корь: наличие лихорадки, кашля, боли в горле, насморка, конъюнктивита и лимфаденита. Пятна коплика могут предшествовать генерализованной сыпи.
- Риккетсиоз: характеризуется появлением лихорадки, головной боли, миалгии и центростремительной непрюригинальной макулопапулезной экзантемы. Осложнения включают геморрагическое суфозирование, геморрагическую, дыхательную недостаточность, почечную недостаточность, неврологические нарушения и шок.
- Малярия: периодическая лихорадка, пароксизм, почечная недостаточность, желтуха, измененные уровни сознания, гепатомегалия или спленомегалия и история воздействия в зонах передачи.
- Лептоспироз: тяжелая миалгия, глазное кровотечение, рубиновая желтуха, олигурия и субконъюнктивальное кровоизлияние. История воздействия загрязненной воды.
Таблица 2 Дифференциальный диагноз денге, зика и чикунгунья в симптоматических случаях
Таблица в натуральную величину
Во многих недавних публикациях подчеркивается наличие двойных инфекций, в том числе сопутствующих инфекций Зика и Денге и Зика и Чикунгунья (47-51). В связи с постоянным распространением этих вирусов и относительно похожими клиническими проявлениями крайне необходимо наличие молекулярных платформ для более точной диагностики.
Лабораторная диагностика
Типы имеющихся лабораторных образцов и необходимые образцы
Специфический лабораторный диагноз основывается главным образом на обнаружении вирусной РНК из клинических образцов. В образцах крови обнаружение возможно в течение 1-5 дней после появления симптомов (52, 53). Отрицательные результаты не исключают диагноз, потому что чувствительность ОТ-ПЦР оценивается в 40%.
Из-за большей персистенции вируса в моче пациентам, наблюдаемым после пятого дня заболевания, следует провести RT-PCR на моче. Этот анализ показан до 15-го дня после начала симптомов (52, 53).
Обычно считается, что серологические тесты способны обнаруживать IgM с 4-го дня и IgG с 12-го дня.
Серологические тесты на Зика в популяциях с одновременным или предшествующим распространением других флавивирусов могут быть неточными из-за риска перекрестных реакций, что приводит к ложноположительным результатам. По этой причине положительные результаты следует анализировать с осторожностью, поскольку они могут представлять собой предыдущее воздействие других флавивирусов (таких как вирус денге) или вакцинацию в прошлом против желтой лихорадки или японского энцефалита (52, 53).
Отрицательные серологические результаты (нереактивные IgM и IgG) позволяют предположить, что инфекции не произошло, если тест проводился через 2-12 недель после воздействия (53). На рисунке 1 приведено краткое изложение рекомендаций для лабораторной диагностики вирусной инфекции Зика. В таблицах 3, 4 и 5 приведены рекомендации по сбору, хранению, сохранению и транспортировке серологических образцов, выделению вируса и молекулярной диагностике в подозреваемых случаях Zika.

Краткое изложение рекомендаций по специфической диагностике Зика
Изображение в полном размере
Таблица 3 Рекомендации по сбору, хранению, хранению и транспортировке серологических образцов, выделению вируса и молекулярной диагностике в подозреваемых случаях Зика
Таблица в натуральную величину
Таблица 4 Инструкции по сбору и отправке образцов для лабораторной диагностики - для серологической диагностики
Таблица в натуральную величину
Таблица 5 Инструкции по сбору и отправке образцов для лабораторной диагностики - для диагностики с помощью ОТ-ПЦР
Таблица в натуральную величину
В руководящих принципах Министерства здравоохранения Бразилии определено собирать образцы из первых случаев в области, в которой нет лабораторного подтверждения острого вирусного заболевания Зика, от 100% (всех) беременных женщин с подозрением на острое вирусное заболевание Зика, от 100% (всех) смертельные случаи, предположительно вызванные острым вирусным заболеванием Зика и от 100% (всех) пациентов, госпитализированных в дозорные отделения, с неврологическими проявлениями и с подозрением на предшествующую вирусную инфекцию (Зика, денге и чикунгунья).
Интерпретация результатов
- Положительный молекулярный тест подтверждает диагноз Зика.
- Отрицательный молекулярный тест не исключает возможности Зика.
- Реактивный серологический тест на Зика может быть вызван острой инфекцией вирусом, перекрестной реакцией с другими флавивирусами или результатом вакцинации против желтой лихорадки.
Управление делом
Управление острым синдромом Зика
Специального противовирусного лечения не существует.
Лечение состоит из отдыха, перорального увлажнения и использования лекарств от симптомов.
Анальгетики и жаропонижающие средства, такие как дипирон и парацетамол.
Антигистаминные препараты для контроля зуда.
Нестероидные противовоспалительные препараты (НПВП) не следует применять до тех пор, пока не будет исключен диагноз денге (54). Избегайте их использования у беременных после 32-й недели беременности из-за риска раннего закрытия артериального протока.
Избегайте использования аспирина у детей в возрасте до 12 лет из-за риска синдрома Рейе.
Важно оценить дифференциальные диагнозы, особенно в связи с лихорадкой денге, из-за большего риска развития серьезных случаев. Лечите все случаи как лихорадку денге, пока этот диагноз не будет исключен.
Ведение беременных
В настоящее время доступны только ограниченные данные о беременных женщинах, инфицированных вирусом Зика. Данные предполагают, что беременные женщины могут заразиться вирусом Зика в любом триместре. Тем не менее, заболеваемость вирусом Зика среди беременных женщин неизвестна. Нет данных, позволяющих предположить, что беременные женщины более восприимчивы к Зика или что у них заболевание более тяжелое, чем у других людей (55).
Что касается передачи вируса Зика, существуют свидетельства передачи вируса от матери к плоду во время беременности, а также вблизи времени родов. Поскольку не существует вакцин или профилактических препаратов для предотвращения заражения вирусом Зика, Бразильское общество инфекционистов (ВОО) рекомендует (в соответствии с Центрами по контролю и профилактике заболеваний, CDC), что женщины в любом триместре беременности должны отложить поездки в районы с передача этого вируса. Если беременная женщина живет или путешествует в область с вирусом Зика, она должна защищаться, чтобы избежать укусов комаров.
Беременным женщинам с симптомами, совместимыми с Зика (включая жар, высыпания на коже, боли в суставах и покраснение глаз), необходимо уделять приоритетное внимание лабораторным исследованиям для диагностики инфекции вирусом Зика.
Министерство здравоохранения Бразилии не рекомендует рутинное пренатальное использование серологических тестов на Зика среди беременных женщин, живущих в районах с эпидемией Зика.
Центры по контролю и профилактике заболеваний (CDC) рекомендует
- Если лабораторный тест положительный на Зика или неубедительный, следует рассмотреть возможность использования серийных ультразвуковых исследований.
- Для беременных женщин, у которых у плода подтвержденный диагноз микроцефалия, возможность амниоцентеза следует оценивать с 15-й недели беременности.
- Беременные женщины в зоне передачи должны проходить серологические тесты на Зика в начале своей дородовой помощи.
- Серологические тесты должны быть предложены женщинам в районах без автохтонной передачи, если у них был опыт поездок в район с известной передачей вируса Зика и они протекали бессимптомно (т.е. без сообщений о болезни, согласующейся с Зика). Эти тесты должны проводиться через 2-12 недель после поездки.
Бразильская федерация гинекологических и акушерских ассоциаций (FEBRASGO) рекомендует следующее в случаях беременных женщин с клиническими проявлениями Zika:
Ультразвуковое исследование следует назначать каждый месяц до родов (56)
Американское общество гинекологии и акушерства рекомендует следующее в случаях беременных женщин с серологическими результатами, которые являются положительными для Зика или неубедительными, и / или которые показывают симптомы инфекции Зика:
- Если во время симптомов или серологических тестов беременная женщина не достигла 20-й недели беременности, ультразвуковое обследование должно назначаться каждые 3-4 недели, начиная с 18-й недели.
- Если во время симптомов или серологических тестов у беременной женщины уже нет 20-й недели беременности, ультразвуковое обследование должно назначаться каждые 3-4 недели, начиная с момента постановки диагноза.
Краткое изложение текущих рекомендаций по диагностике вирусной инфекции Зика у беременных женщин показано на рис. 2. На рис. 3 представлен алгоритм диагностики различных арбовирусных заболеваний у беременных.

Резюме рекомендаций по специфической диагностике Зика у беременных
Изображение в полном размере

Алгоритм диагностики различных арбовирусных заболеваний у беременных
Изображение в полном размере
Управление микроцефалией и врожденными пороками развития
Очень важно записать гестационный возраст при рождении при оценке размера черепа у новорожденных (57).
INTERGROWTH-21 позволяет измерять окружность головы при рождении во многих различных популяциях и была получена с помощью строгой методологии и стандартизированных процедур. Это очень важно в контексте вспышки вируса Зика, поскольку для скрининга на микроцефалию требуется достоверная информация об окружности головы новорожденных в зависимости от их гестационного возраста (57).
Критерии уведомления новорожденного с микроцефалией в соответствии с рекомендациями Министерства здравоохранения (9):
- Новорожденные с гестационным возрастом менее 37 недель, у которых измерение окружности головы составляет менее -2 стандартных отклонений для гестационного возраста и пола, как описано в таблице InterGrowth.
- Новорожденные с гестационным возрастом 37 недель и более, у которых измерение окружности головы составляет менее или равно 31, 5 см для девочек и 31, 9 для мальчиков, что эквивалентно менее чем -2 стандартным отклонениям для возраста и пола новорожденного, как описано в таблица ВОЗ.
Согласно ВОЗ и международной литературе, микроцефалия определяется как окружность головы, составляющая менее чем минус два стандартных отклонения относительно пола, возраста или длины беременности. Окружность головы должна быть измерена с использованием стандартизированной техники и оборудования между 24 и 6 днями через 23 часа после рождения (т.е. в течение 1-й недели жизни).
Тяжелая микроцефалия определяется как окружность головы менее чем -3 стандартных отклонения, то есть более чем на три стандартных отклонения ниже среднего значения для гестационного возраста и пола.
По данным ВОЗ, новорожденные с микроцефалией, у которых имеются структурные аномалии головного мозга, диагностированные с помощью визуализации или наблюдаемых неврологических расстройств или патологий развития, должны классифицироваться как имеющие «микроцефалию с аномалиями головного мозга». Все новорожденные с микроцефалией должны регулярно проходить оценку и наблюдение в детстве, в том числе: рост головы, историю беременности матери и семьи, оценку развития и физические и неврологические обследования, включая оценку слуха и зрения, для выявления любых проблем. Для выявления структурных аномалий головного мозга ВОЗ рекомендует проводить ультразвуковые исследования трансфонтанеллы, когда размер родничка достаточен для этой процедуры. Для новорожденных с тяжелой микроцефалией (-3 стандартных отклонения) следует выполнять компьютерную томографию головного мозга или магнитно-резонансную томографию.
Микроцефалия может сопровождаться эпилепсией, церебральным параличом, задержкой когнитивного, моторного и речевого развития, а также проблемами слуха и зрения.
Специального лечения микроцефалии не существует. Поскольку у каждого ребенка развиваются осложнения, которые различаются по типу и степени тяжести, которые могут включать в себя респираторные, неврологические и двигательные проблемы, наблюдение за различными специалистами будет зависеть от того, какие функции были скомпрометированы.
Краткое изложение текущих рекомендаций по диагностике вирусной инфекции Зика у новорожденных показано на рис. 4.

Резюме рекомендаций по специфической диагностике Зика у новорожденных
Изображение в полном размере
Управление синдромом Гийена-Барре
Из-за аутоиммунной природы синдрома Гийена-Барре его лечение в острой фазе состоит из иммунотерапии, такой как плазмаферез или применение иммуноглобулина человека. Когда кортикостероиды используются отдельно, это не ускоряет выздоровление и не меняет долгосрочный результат (58).
Целью плазмафереза является удаление антител из кровотока и замена их искусственной плазмой, обычно альбумином. Результат лучше, когда процедура начинается в течение первых 7-14 дней после появления неврологических симптомов (58).
Человеческий иммуноглобулин ускоряет выздоровление, что наблюдается при плазмаферезе. Это относительно просто для администрирования. Наилучшие результаты достигаются, когда он начинается в течение первых 2 недель после появления симптомов (58).
Эндовенозная доза иммуноглобулина человека: 400 мг / кг массы тела в день в течение 5 дней.
Диагностика синдрома Гийена-Барре (42):
- История болезни и неврологическое обследование.
- Сбор спинномозговой жидкости, в которой ожидается обнаружение повышенной концентрации белка, в ущерб повышенной клеточности.
- Пациенты с подозрением на синдром и клеточность более 50 клеток / мм 3 должны быть обследованы на предмет другой этиологии или сопутствующей ВИЧ-инфекции.
- Спинномозговая жидкость может быть нормальной в сверхострой фазе (первая неделя).
- Электронейромиография - это обследование, подтверждающее диагноз, но оно может быть нормальным на 1-й неделе.
- Визуальные обследования обычно нормальные.
Меры контроля общественного здравоохранения
Меры борьбы с переносчиками:
- Основные санитарные условия.
- Устранение векторных очагов в домах и местах общего пользования.
- Сокращение накопления мусора с помощью городских очистительных кампаний в районах, где сбор мусора происходит нерегулярно, а также за счет увеличения частоты сбора мусора.
- Осуществление борьбы с переносчиками посредством физических, биологических и химических методов с участием семей и сообществ.
- В районах с автохтонной передачей или импортированными случаями передачи денге, чикунгуньи и / или зика, в дополнение к применению личиночных препаратов, рекомендуется блокирование случаев с помощью пестицидов, предназначенных для взрослых переносчиков, главным образом путем распыления.
- Полевые работы, проводимые агентами по эндемическим болезням для борьбы с личинками и взрослыми комарами, должны контролироваться и контролироваться.
- Борьба с комарами является единственной мерой, которая может прервать передачу арбовирусных заболеваний, таких как Зика, денге и чикунгунья.
Профилактика и личная защита
Чтобы не заразить других людей, инфицированные должны защищать себя от укусов Aedes в течение 1-й недели (фаза виремии).
До сих пор нет вакцины для предотвращения заражения вирусом Зика.
Шаги по предотвращению укусов комаров
- Используйте рубашки с длинными рукавами и длинные брюки / штаны.
- Оставайтесь в закрытых местах с кондиционером или в местах с окнами и дверями, в которых есть экраны для предотвращения попадания комаров.
- Спите под противомоскитными сетками.
-
Используйте зарегистрированные средства от насекомых. Когда они используются в соответствии с инструкциями, они безопасны и эффективны даже во время беременности или кормления грудью.
- Всегда следуйте инструкциям листовок с инструкциями.
- Избегайте использования продуктов, которые сочетают репеллент и защиту от солнца в одной рецептуре. Солнцезащитный фактор уменьшается на треть при использовании вместе с репеллентом от насекомых.
- Если используется защита от солнца, нанесите ее перед применением репеллента.
-
Для детей
- Не используйте репеллент для детей в возрасте до 2 месяцев.
- Оденьте детей в одежду, которая закрывает их руки и ноги.
- Накройте детские кроватки и коляски противомоскитными сетками.
- Не наносите репеллент на детские руки.
-
Можно использовать одежду, пропитанную перметрином.
Не используйте продукты, содержащие перметрин, непосредственно на коже.
В Бразилии Национальное агентство по надзору за здоровьем (ANVISA) рекомендует использовать репелленты только для детей старше 6 месяцев. Центры по контролю и профилактике заболеваний (CDC) рекомендуют их использовать с возраста 2 месяцев, за исключением эвкалипта лимона, который следует использовать только с возраста 3 лет.
Объявления
Мы считаем, что наша статья «Управление инфекцией вирусом Зика» должна быть опубликована в «Анналах клинической микробиологии и противомикробных препаратов», поскольку она является официальным документом Бразильского общества инфекционных заболеваний и содержит рекомендации по борьбе с этой инфекцией, основанные на опыте бразильского Специалисты по инфекционным заболеваниям приобрели после столкновения с этой эпидемией. В этом документе также рассматриваются самые последние научные данные о передаче вируса Зика и клинических особенностях. Мы намерены представить эту статью для специального приложения об арбовирусах в Анналах клинической микробиологии и противомикробных препаратов.
Все авторы заявляют об отсутствии конкурирующих интересов и подтверждают, что одобрили рукопись для представления. Мы также подтверждаем, что содержание рукописи не было опубликовано или передано для публикации в другом месте.
Сокращения
- КТО:
- Всемирная организация здоровья
- РНК:
- рибонуклеиновая кислота
- ПЦР:
- полимеразной цепной реакции
- IgM:
- иммуноглобулин М
- ОТ-ПЦР:
- полимеразная цепная реакция в реальном времени
- GBS:
- Синдром Гийена-Барре
- НПВС:
- нестероидный противовоспалительный препарат
- ВОО:
- Sociedade Brasileira de Infectologia
- CDC:
- Центры по контролю и профилактике заболеваний
- FEBRASGO:
- Федерация бразильской гинекологии и акушерства
- ANVISA:
- Agência Nacional de Vigilância Sanitária